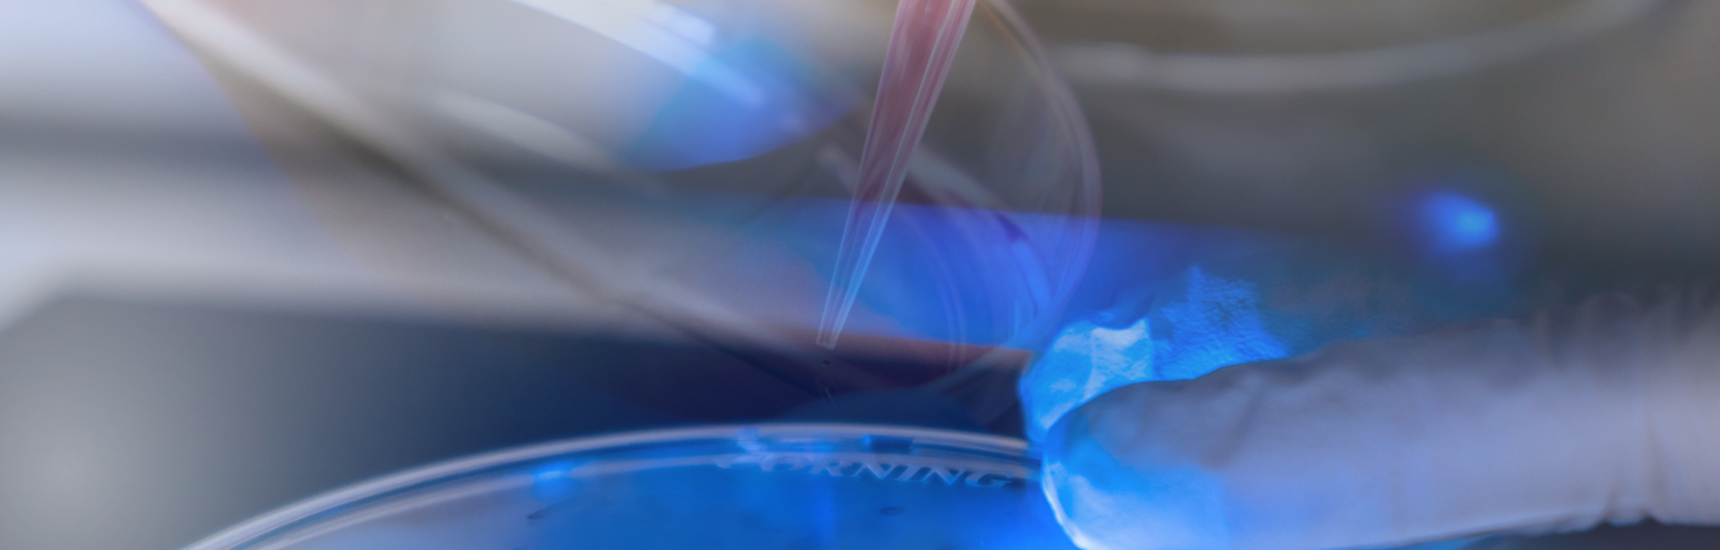
CD-Labor

Video-Rundgang durch das Labor
Die feierliche Eröffnung des neuen Christian-Doppler-Labors für Aktivierung des immunogenen Zelltods bei Lungenkrebs fand gestern in der Aula der Medizinischen Universität Graz statt. Zahlreiche Vertreter*innen aus Wissenschaft, Wirtschaft und Politik nahmen an der Veranstaltung teil und unterstrichen damit die hohe Relevanz des neuen Forschungslabors für die Weiterentwicklung innovativer Krebstherapien.
Die Veranstaltung wurde durch Rektorin Andrea Kurz offiziell eröffnet. In ihren Worten betonte sie die Bedeutung der Christian-Doppler-Labore als Brücke zwischen exzellenter Grundlagenforschung und industrieller Anwendung. Im Anschluss folgten Grußworte von Peter Prenninger, Vizepräsident der Christian Doppler Forschungsgesellschaft & AVL List GmbH, Akos Heinemann, Vizerektor für Forschung der Med Uni Graz, Lars-Peter Kamolz, Stellvertretender Ärztlicher Direktor des Universitätsklinikums Graz, Alexander Rosenkranz, Vizerektor für Klinische Angelegenheiten, Innovation und Nachhaltigkeit der Med Uni Graz sowie Mark Pearson, Senior Scientific Director External Innovation, Boehringer Ingelheim RCV. Alle Redner hoben die strategische Bedeutung des neuen CD-Labors hervor – insbesondere im Hinblick auf die Entwicklung neuer Therapieansätze für das nicht-kleinzellige Lungenkarzinom (NSCLC), eine der weltweit häufigsten und aggressivsten Tumorarten. Ein Video-Rundgang bot den Gästen erste Eindrücke der Forschungsinfrastruktur und der wissenschaftlichen Schwerpunkte des Labors. Im Anschluss präsentierten die beiden Principal Investigators Michael Dengler und Philipp Jost ihre Forschungsprogramme. Beide betonten, wie wichtig es ist, Mechanismen der immunogenen Zellsterblichkeit besser zu verstehen, um Tumorzellen für das Immunsystem „sichtbarer“ zu machen und so langfristig wirksamere Therapien zu entwickeln. Als wissenschaftlicher Höhepunkt folgte die Keynote von Ulrich Keller (Charité Berlin), der über aktuelle Herausforderungen und Chancen der klinischen Translation in der Krebsmedizin sprach. Er zeigte auf, wie eng Grundlagenforschung, klinische Studien und industrielle Entwicklung verzahnt sein müssen, um neue Therapien erfolgreich zu Patient*innen zu bringen. Nach den abschließenden Worten der Laborleiter bot ein Flying Dinner Gelegenheit zum Austausch. Die Gäste nutzten die Möglichkeit, sich zu vernetzen und zukünftige Kooperationen zu vertiefen.















